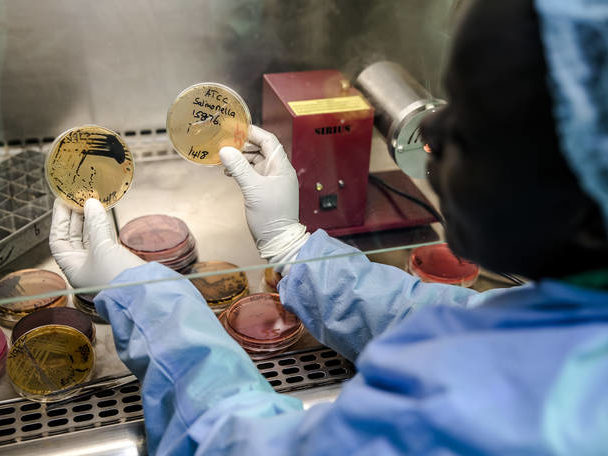

One Health
Workforce Academies
Training and Empowering the Current and Future Workforce
Earn accreditation and employer recognition of One Health training, core competencies, and technical skills
The One Health Workforce Academies are supported by a consortium of public and private partners.
IMPORTANT NOTICE
OHWA is on a hiatus starting
September 21, 2025.
New course registrations have been suspended.
We are grateful to the educators and practitioners who leant their talents to the creation of the OHWA, and to the global community of the learners who utilized OHWA’s educational resources. Your participation demonstrated the value of accessible and timely One Health content. Taking time on hiatus will allow us to regroup given shifting funding landscapes, and we will be actively investigating future possibilities for re-engaging with the global One Health education space.
All Training Materials are Now Open
Enhance your One Health skills and register today!
Anyone with a free OHWA account may access our training materials. Register Now. Case studies, Facilitator Guides, and Tool Kits may be accessed without enrollment. Online Courses require enrollment. You may enroll at any time and there are no prerequisites for participation. Courses will be immediately accessible after enrollment. Click on the “Enroll Now” button to access the course(s) of your choice.

One Health and Gender
This course spans 6 modules and provides a thorough introduction to concepts, like gender and sex, and how they relate to One Health. Each module consists of assigned readings and videos, a case study or activity for the student to complete as they go through the module, specific lessons that pertain to the module subject, and a quiz.

Introduction to Health Care Quality and Quality Improvement
This expansive online asynchronous training course spans 9 modules representing key elements for quality and quality improvement programs in global HIV programs. Each module is comprised of learning objectives, topics of key concepts, specific lessons related to the subject matter, and a quiz to assess learner competency. Examples of quality improvement approaches, methods and tools implemented in real life settings- provide the learner with the knowledge to implement quality improvement activities in their own setting.

Antimicrobial Resistance in One Health: Advanced Level
This dynamic training course spans six online modules and provides comprehensive coverage of surveillance systems, AMR assessment, laboratory diagnosis and AMR countermeasures such as infection prevention and control (IPC) and antimicrobial stewardship (AMS).
Antimicrobial Resistance in One Health: Introductory Level
This dynamic training course spans 5 online modules and provides an introduction to the principles, causes, and applications of AMR in the One Health sectors.

An Introduction to Grant Writing
This asynchronous course introduces participants to the basics of scientific grant writing and management. The contents of this course are organized across five distinct modules, each comprised of several brief video lectures recorded by experts from across the globe, followed by a short quiz to assess learner competency.

Preventing and Addressing COVID-19
This course was developed to provide training to health care providers and others working in healthcare facilities who are involved in the frontline management of COVID-19 in a resource limited setting. These training modules focus on recognition of the signs and symptoms of COVID-19, diagnostic testing, infection prevention and control measures, supporting community engagement and long term measures to address COVID-19.

Virtual Communities of Practice
The concept of virtual Communities of Practice ( vCoPs) has recently gained popularity to bridge distance via technology for individuals and groups with an interest in a common topic. VCoPs are a great way to share experiences, best practices and to problem solve in a specific area for peers and experts by meeting regularly providing training in a low dose high frequency approach.

Risk Communication & Community Engagement
This dynamic training course spans 11 online modules and provides a basic introduction to the principles and concepts of a comprehensive One Health approach to risk communication related to a disease outbreak (or other disease event in animals or people) and how to engage communities around risks of disease transmission and behavior change.

Outbreak Investigation and Response
This dynamic training course spans 11 online modules and provides a basic introduction to the principles and concepts of a comprehensive One Health approach to investigating the origins or cause of a zoonotic disease outbreak or other disease event in animals or people.

Fundamentals of One Health Practice
Based on results from an international stakeholder survey and expert Delphi panel, the Fundamentals of One Health Practice course strengthens technical and competency-based knowledge and skill sets of One Health professionals.
Certification
COMING SOON
The One Health Workforce Academies provides training opportunities for all pre-service trainees at or beyond the bachelor’s degree programs at their universities or other academic institutions. Those pursuing a master’s degree in public health, environmental science, a doctorate in veterinary medicine, human medicine, pharmacy, or any other health profession are welcome to explore the academies’ training opportunities and study for and acquire your credential certification in One Health.
In-service trainees currently employed in agencies, institutions, government offices, and research programs dedicated to implementing the One Health framework can document their expertise through the One Health certificate.
Once available, information on this website will guide you in preparing for the One Health certification exam, acquiring continuing professional development credit opportunities, and maintaining your certification.
Global Partners
Explore the diverse training opportunities available to you through the global One Health community.
Learn More
Contact Us
Interested in OHWA but have questions. Contact us to learn more about OHWA, our training, and certification.
Contact Us
DONATE
Your support of the foundation and activities of the OHWA ensures that our team of professionals can continue to provide the development, delivery, institutionalization, accreditation, and employer-recognition of the valuable work we are doing.
You can use your email receipt for your tax-deducatable donations!